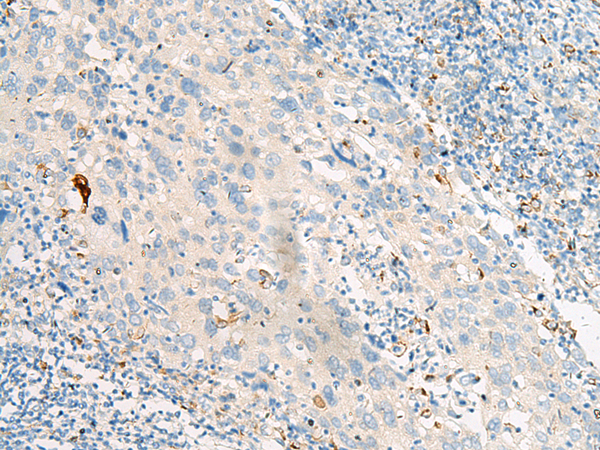
一抗

|
Background: |
This gene encodes a G protein-coupled receptor (GPR) which belongs to the rhodopsin family of GPRs. The encoded protein functions as a receptor for free fatty acids, including omega-3, and participates in suppressing anti-inflammatory responses and insulin sensitizing. Multiple transcript variants encoding different isoforms have been found for this gene. |
|
Applications: |
ELISA, IHC |
|
Name of antibody: |
FFAR4 |
|
Immunogen: |
Synthetic peptide of human FFAR4 |
|
Full name: |
free fatty acid receptor 4 |
|
Synonyms: |
GT01; PGR4; BMIQ10; GPR120; GPR129; O3FAR1 |
|
SwissProt: |
Q5NUL3 |
|
ELISA Recommended dilution: |
5000-10000 |
|
IHC positive control: |
Human colorectal cancer and Human cervical cancer |
|
IHC Recommend dilution: |
20-100 |


 購物車
購物車 幫助
幫助
 021-54845833/15800441009
021-54845833/15800441009